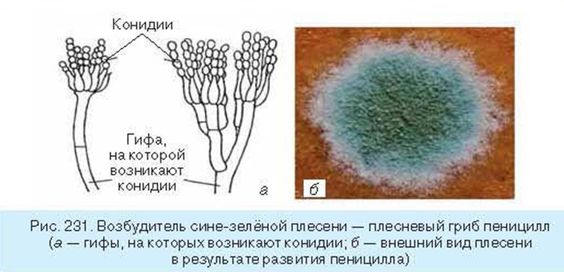

СХЕМИ-МАЛЮНКИ
Ботаніка
ВступЗбільшувальні прилади Клітина рослинТканини рослин Корінь Пагін Стебло ЛистКвітка Суцвіття ЗапиленняЗапліднення НасінинаПлід Процеси, що відбуваються у рослин Вегетативне розмноження Подразливість та рухи Водорості Мохоподібні ПлауноподібніХвощеподібні Папоротеподібні Голонасінні ОднодольніДводольні ЗлаковіЦибулеві Лілійні Капустяні (Хрестоцвіті) Розові Бобові Пасльонові Айстрові (Складноцвіті) Гриби ЛишайникиПрокаріоти Одноклітинні еукаріоти Систематика Рослини і фактори довкілля Охорона рослин

Зоологія
Анатомія
Загальна біологія
ВступХімічні елементиВодаМінеральні соліВуглеводиЛіпідиБілкиНуклеїнові кислотиАТФБіологічно активні речовиниМетоди цитолоіїПоверхневий апарат (надмембранний комплекс, клітинна мембрана, транспорт, підмембранний комплекс)Немембранні органелиОдномембранні органелиДвумембранні органелиЯдро, хромосомиКлітина бактерійКлітина рослинКлітина тваринКлітина грибівГліколізДиханняБродінняФотосинтезХемосинтез









Репликация

































































































































































